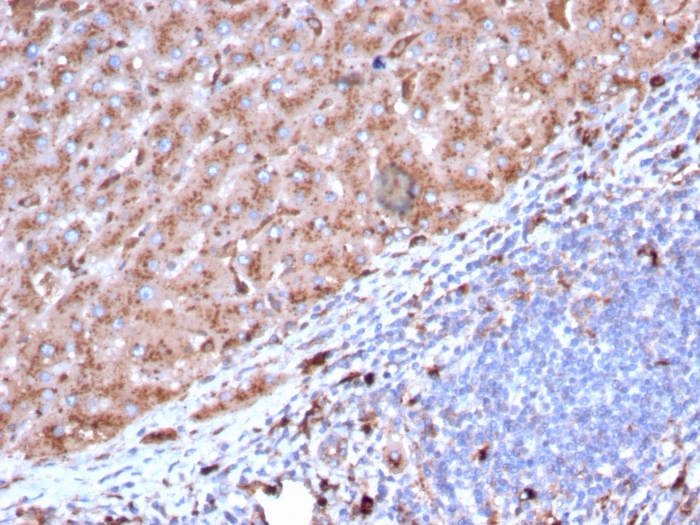

Formalin-fixed, paraffin-embedded human liver stained with Cathepsin D Mouse Monoclonal Antibody (CTSD/3082).
Formalin-fixed, paraffin-embedded human liver stained with Cathepsin D Mouse Monoclonal Antibody (CTSD/3082).

Formalin-fixed, paraffin-embedded human liver carcinoma and macrophages stained with Cathepsin D Mouse Monoclonal Antibody (CTSD/3082).

SDS-PAGE Analysis Purified Cathepsin D Mouse Monoclonal Antibody (CTSD/3082). Confirmation of Purity and Integrity of Antibody.

Analysis of Protein Array containing more than 19,000 full-length human proteins using Cathepsin D Mouse Monoclonal Antibody (CTSD/3082) Z- and S- Score: The Z-score represents the strength of a signal that a monoclonal antibody (MAb) (in combination with a fluorescently-tagged anti-IgG secondary antibody) produces when binding to a particular protein on the HuProtTM array. Z-scores are described in units of standard deviations (SD's) above the mean value of all signals generated on that array. If targets on HuProtTM are arranged in descending order of the Z-score, the S-score is the difference (also in units of SD's) between the Z-score. S-score therefore represents the relative target specificity of a MAb to its intended target. A MAb is considered to specific to its intended target, if the MAb has an S-score of at least 2.5. For example, if a MAb binds to protein X with a Z-score of 43 and to protein Y with a Z-score of 14, then the S-score for the binding of that MAb to protein X is equal to 29.
Cathepsin D is a ubiquitously expressed lysosomal aspartyl protease involved in the normal degradation of proteins. It is synthesized as an inactive 52kDa preprocathepsin D that is cleaved and glycosylated to form a 48kDa procathepsin D and then further cleaved to produce 34kDa and 14kDa subunits (heavy and light chains, respectively). Cathepsin D exhibits pepsin-like activity and plays a role in protein turnover and in the proteolytic activation of hormones and growth factors. Mutations in this gene play a causal role in neuronal ceroid lipofuscinosis-10 and may be involved in the pathogenesis of several other diseases, including breast cancer and possibly Alzheimer’s disease.
There are no reviews yet.